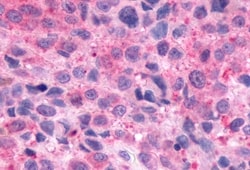
Invitrogen Opsin 3 Polyclonal Antibody 50 &mu;g; Unconjugated:Antibodies,
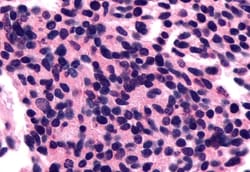
Invitrogen Opsin 3 Polyclonal Antibody 50 &mu;g; Unconjugated:Antibodies,

missing translation for 'onlineSavingsMsg'
Learn More
Learn More
Invitrogen™ Opsin 3 Polyclonal Antibody


Rabbit Polyclonal Antibody
Brand: Invitrogen™ PA534038
This item is not returnable.
View return policy
Description
Percent identity with other species by BLAST analysis: Human, Gibbon, Monkey (100%) Dog, Panda (95%) Marmoset, Rat, Elephant (89%) Mouse, Horse (84%).
Opsins are members of the guanine nucleotide-binding protein (G protein)-coupled receptor superfamily. In addition to the visual opsins, mammals possess several photoreceptive non-visual opsins that are expressed in extraocular tissues. This gene, opsin 3, is strongly expressed in brain and testis and weakly expressed in liver, placenta, heart, lung, skeletal muscle, kidney, and pancreas. The gene may also be expressed in the retina. The protein has the canonical features of a photoreceptive opsin protein. May play a role in encephalic photoreception. Strongly expressed in brain. Highly expressed in the preoptic area and paraventricular nucleus of the hypothalamus. Shows highly patterned expression in other regions of the brain, being enriched in selected regions of the cerebral cortex, cerebellar Purkinje cells, a subset of striatal neurons, selected thalamic nuclei, and a subset of interneurons in the ventral horn of the spinal cord.
Specifications
| Opsin 3 | |
| Polyclonal | |
| Unconjugated | |
| Opn3 | |
| ECPN; Encephalopsin; ERO; NMO-1; Opn3; opsin (encephalopsin); opsin 3; opsin 3 (encephalopsin, panopsin); opsin-3; Panopsin; PPP1R116; protein phosphatase 1, regulatory subunit 116 | |
| Rabbit | |
| Antigen affinity chromatography | |
| RUO | |
| 23596 | |
| Store at 4°C short term. For long term storage, store at -20°C, avoiding freeze/thaw cycles. | |
| Liquid |
| Immunohistochemistry (Paraffin) | |
| 1 mg/mL | |
| PBS with 0.1% sodium azide | |
| Q9H1Y3 | |
| Opn3 | |
| Synthetic 19 amino acid peptide from C-terminus of human OPN3 / Encephalopsin. | |
| 50 μg | |
| Primary | |
| Human, Monkey | |
| Antibody | |
| IgG |
Product Content Correction
Your input is important to us. Please complete this form to provide feedback related to the content on this product.
Product Title
Spot an opportunity for improvement?Share a Content Correction